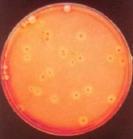

総合1位【LINE登録で最大1000円OFF】プロテイン ビーレジェンド ホエイプロテイン 女性 男性 WPC チョコ ベリー バナナ メロン 抹茶 鬼レモン パッションフルーツ ヨーグルト マンゴー 1kg WPC ゲリラ
3,980円
11530 customer ratings
4.6 ★★★★★
ナチュラル ミルク チョコ バナナ キャラメル珈琲 ベリー メロン 抹茶 いちご パッションフルーツ 鬼レモン ピーチ マンゴー ヨーグルト から選べる ↑LINE登録はこちらから↑ ■フレーバー紹介 ・ ナチュラル (さわやかミルク風味) ほんのり甘さが広がるさっぱり ミルク…




![[500円OFF 100円OFFクーポン配布中] エクエル パウチ 120粒入り 大塚製薬 エクオール [ 正規品 送料無料 ] 4粒で S-エクオール 10mg 120粒 エクオール 大豆イソフラボン サプリ / EQUELLE エクエル大塚製薬 エクオル 最安値 挑戦中 [メール便]](https://thumbnail.image.rakuten.co.jp/@0_mall/pycno/cabinet/cmp/sale01/0302event-eq_05.jpg?_ex=145x145)
![【ポイント10倍 3/4 20:00-3/11 01:59】 [期間限定 LINE登録で1,000円OFF] VALX ホエイプロテイン WPC 1kg 選べる8種フレーバー 国内生産 山本義徳 チョコレート ベリー ヨーグルト カフェオレ バナナ 抹茶 プロテイン タンパク質 筋トレ ダイエット 美容 置き換え 女性](https://thumbnail.image.rakuten.co.jp/@0_mall/valx/cabinet/tmb/friend_pt10/wpc1kg_pt10.jpg?_ex=145x145)
















.jpg)